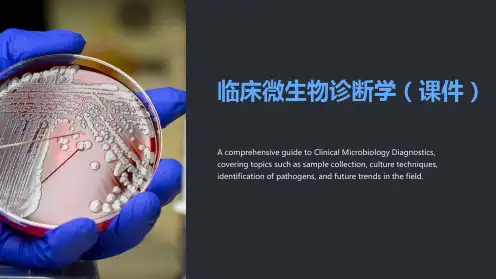

Sample Collection and Handling in Microbiology Diagnostics
Learn about the proper techniques and considerations for sample collection, transportation, and storage in clinical microbiology diagnostics, ensuring accurate and reliable results.
Automated Microbiology Systems and Their Use in Clinical Diagnostics
Learn about the latest advancements in automated microbiology systems, such as MALDI-TOF mass spectrometry and automated antimicrobial susceptibility testing platforms, enhancing the efficiency and accuracy of clinical diagnostics.
Serological and Immunological Techniques in Microbiology Diagnostics
Explore the use of serological and immunological techniques, such as ELISA, agglutination assays, and immunoassays, in the diagnosis of infectious diseases and the detection of specific antibodies or antigens.